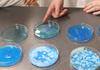
Geology with the Year 8's Banner Photo

Beaufort Secondary College Newsletter
Respectful Relationships - High Expectations - Excellence
We acknowledge the Wadawurrung People as the Traditional Owners of this land along with their continuing connection to Land, Waters and Culture.
We pay our respect to their Ancestors and Elders past, present and emerging.
Issue 7 · 19 May 2022
In this issue
Published by Beaufort Secondary College